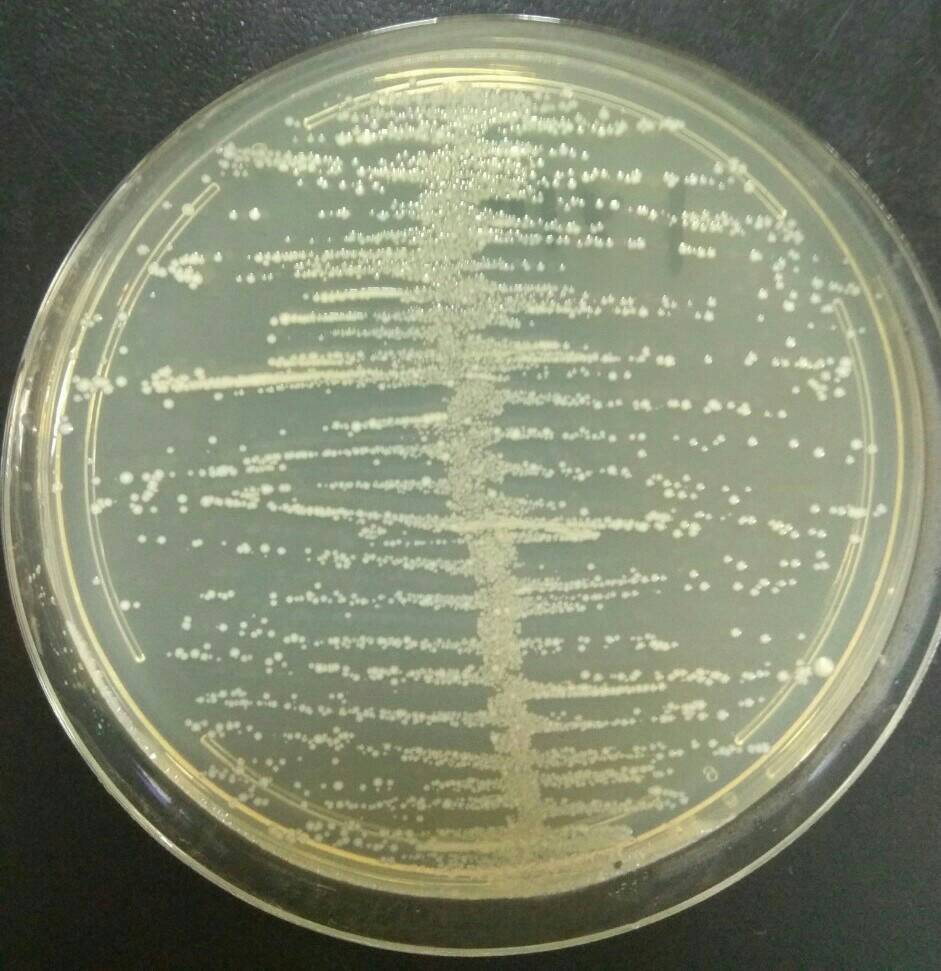
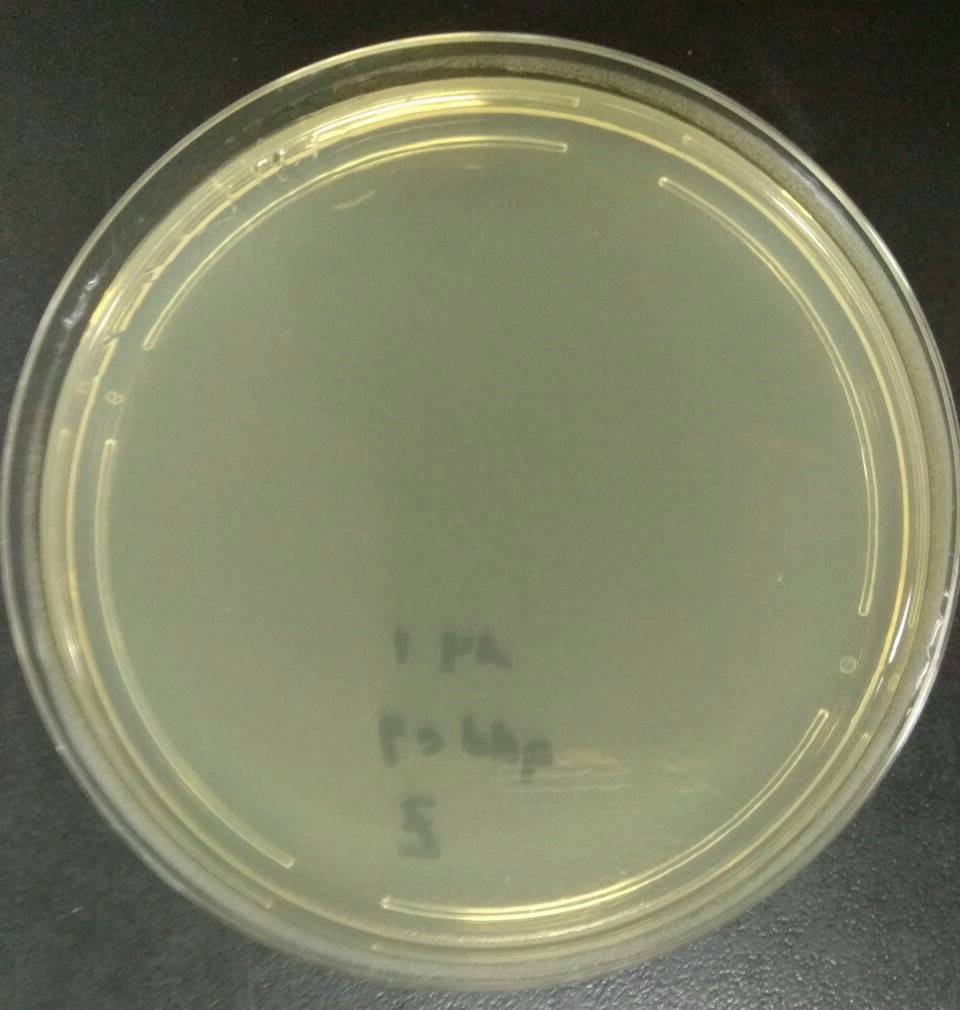

水产养殖
纳米银产品描述
-银离子在水产养殖中的先进应用
1. 预防疾病:广域抗病毒/抗菌。
2. 预防消毒:底池,水,转池的鱼/虾。
3. 水处理:控制有害藻类,亚硝酸盐,改善水色。
4. 运输和保存:水生生物可能在短时间内变质和变质。
5. 添加到饲料中。
6. 无抗生素残留:低剂量纳米银使用,长效。
AGNP CLEAN ~纳米银水溶液
防疫:细菌、病毒、霉菌、真菌、除臭剂。
纳米离子银水溶液浓度非常高,效率更高,文献说明能更有效地杀灭650多种细菌和病毒。
AGNP CLEAN的纳米胶体银溶液产品系列。它已经很好地分散了,并且易于应用。我们提供10000ppm的含量范围是客户的最大选择。
AGNP CLEAN与传统的化学药物和抗生素相比,没有耐药性和体内残留的问题。已成功应用于水产养殖、农业、畜牧业和环保领域。

对人类动物蛋白的需求持续增长,海洋资源继续枯竭。未来渔业生产的主要动力是水产养殖。但是,高密度养殖和抽取受污染的表层海水,以提高繁殖率引起抗生素的滥用,使水体中的抗生素残留极为严重,并成为用于养殖“抗性细菌”。水产养殖业正在使用不同的创新技术,例如金属纳米颗粒-纳米银广域抗病毒和细菌特性,可用于预防疾病,消毒,水处理,运输和保存等。
白斑病病毒(WSSV)

链球菌病

创伤弧菌(Vibrio)

银离子在水产养殖中的先进应用预防疾病-虾白班病病毒(WSSV-White spot syndrome virus),虾早死症(Early Mortality Syndrome -EMS ),鱼链球菌;消毒-可搭配二氧化氯及BKC消毒效果更好;水处理改善水色;鱼虾运输和保存;添加到饲料中,无抗生素残留;低剂量纳米银使用,长效抑制海洋弧菌。
A. 疾病预防:
- 取代抗生素,奈米银可以广域性抗病毒/细菌/真菌.
如何使用:
类别: 虾-糠虾幼虫到后期幼虫,至成虾/种虾
鱼-鱼苗至成鱼
使用量: 0.2ml 加到1吨水内 (2ppb)
频率: a. 不换水, 每二周乙次
b. 换水换多少水依比例添加
Note:
鱼生病时添加量: 6ml 加到1吨水内 (60ppb)
频率: 换多少水依比例添加
高弧菌量造成的成鱼体表溃疡进而死亡,使用纳米胶体银处理可以降低弧菌量而减少损失
- 纳米银会消耗一些益生菌 , 益生菌补充剂(2-3天后)。
B. 预防消毒:
- 底池、补充水、池中水、环境预防污染.
项目: 鱼塘清理、表面消毒
使用量:0.5mL/m2, 以5ppm浓度稀释后喷洒表面。自然干燥无需重复冲洗,作用时间为24小时。
项目:池塘清理完毕后. (未放苗前)
使用量:2mL/m2, 以20ppm浓度加入池塘水中。灭水中致病微生物并防止微生物滋生。
项目: 日常保养
使用量: 0.2mL/m2, 以20ppb浓度加入池塘水中。每二周乙次.
搭配二氧化氯消毒效果更好:
首先用二氧化氯去除鱼池中的非耐药菌12〜24小时,然后加入0.2ml /吨的纳米银,以长期预防和控制耐药菌。
C. 水质处理:
- 控制有害藻类、降低亚硝酸盐等有害因子浓度、改善水色。
如何使用:
消毒剂本身也是一种水环境改良剂,纳米胶体银主要成分为高浓度的奈米银离子,其杀菌性能远高于常见的氯类、季铵盐、单纯过氧化氢、醛类等消毒剂。
D. 运送保鲜:
- 鱼虾等水产,体内氨基酸酶作用,可能会在短时间内腐败变质。
如何使用:
类别: 虾/鱼苗运送
使用量: 2.5 ml 加到1吨水内 (25ppb)
频率: 单次
类别: 鱼运送
使用量: 5 ml 加到1吨水内 (50ppb)
频率: 单次
E. 添加在饲料内:
- 饲料配方高效、环保、健康、无抗生素饲料是未来趋势.
如何使用:
先以5-10公升的水混合均匀后,再以喷洒的方式和饲料均匀搅拌.
一般预防:
使用量: 每吨饲料添加 500 ml.
频率: 1周喂食1~2天 (请每餐喂食)
发病状态:
使用量: 每吨饲料添加 1000-2500 ml.
频率: 每餐喂食持续到疫情稳定,再改回一般预防浓度。
F. 没有抗生素:
- 纳米银使用低剂量,便可长效抗菌且无耐药性.
NOTE1 : 益生菌补充剂(2-3天后):纳米胶体银会消耗一些益生菌。
NOTE2 : 水消毒效果更好:
首先用二氧化氯去除鱼池中的非耐药菌12〜24小时,然后加入0.2ml /吨的纳米银,以长期预防和控制耐药菌。
水产细菌
水产养殖常见细菌及相关症状见下表。
Pathogenic Bacteria | ||
流行病预防 :
纳米胶体银〜纳米银水溶液对以下细菌,病毒和水产养殖疾病具有良好的防疫作用。

Shrimp
★White Spot Syndrome Virus (WSSV)
★ Syndrome Virus (TSV)
★Early Mortality Syndrome (EMS)
★ monodon-type baculovirus (MBV)
★Cramp Tail Syndrome(CMS)
★Infectious Myonecrosis Virus (IMNV)
★Yellow Vibrio
★ hepatopenaei (EHP)
★ Hepatopancreatitis (NHP)
★ Virus (YHV)
★Infectious Hypodermal and Hematopoietic Necrosis Virus(IHHNV)

Fish
★Nuka bacteria
★Edwards disease
★Various Vibriosis
★Yellow liver disease
★Enterogenous necrosis virus
★Rainbow virus
★Muscle perforation
★Red envelope virus
★Streptococcal disease
★White spot disease
★Fungal infection
抗菌效果测试
生物体:金黄色葡萄球菌
金黄色葡萄球菌
原始接种物
3.1x 105(CFU /毫升)

添加AGNPCLEAN 20ppb
接触时间:60min
抗微活性(%)> 99
添加AGNPCLEAN 20ppb 24HR
接触时间:24HR
抗微活性(%)> 99.9